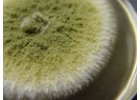

Přípravky na ochranu rostlin
Tato kategorie nabízí širokou škálu přípravků na ochranu rostlin, které jsou speciálně formulovány pro boj proti běžným škůdcům a plísním, jež mohou poškozovat nebo dokonce ničit vaše rostliny.
#ShowMore#
Přípravky na ochranu rostlin proti plísním jsou nezbytné pro prevenci a léčbu různých druhů plísní, které se často objevují v zahradních a skleníkových podmínkách. Tyto produkty jsou formulovány tak, aby byly účinné proti plísním, a zároveň šetrné k rostlinám a životnímu prostředí.
V kategorii přípravků na ochranu rostlin proti škůdcům naleznete produkty určené pro boj s nejrůznějšími škůdci, od hmyzu až po hlodavce. Tyto přípravky jsou navrženy tak, aby účinně eliminovaly nežádoucí organismy, aniž by byly škodlivé pro rostliny nebo životní prostředí.
Vedle chemických prostředků nabízíme i biologické prostředky na ochranu rostlin. Tyto přírodní alternativy jsou šetrné k životnímu prostředí a jsou vynikající volbou pro ty, kteří upřednostňují organické pěstování. Biologické prostředky mohou zahrnovat přírodní predátory škůdců nebo organické repelenty.
K dispozici jsou také lepové desky proti hmyzu, které jsou efektivním a nenáročným řešením pro odchyt malého hmyzu, jako jsou mšice nebo ovocné mušky. Tyto lepové desky jsou snadno použitelné a nabízí okamžitý přehled o přítomnosti škůdců v prostředí vašich rostlin.
Každý produkt v této kategorii je pečlivě vybrán s ohledem na bezpečnost, účinnost a šetrnost k životnímu prostředí. Ať už se jedná o prevenci nebo léčbu, naše produkty na ochranu rostlin poskytují spolehlivé řešení pro udržení vašich rostlin zdravých a silných.
Čtěte v našich článcích na téma ochrany rostlin
Řazení produktů
Výpis produktů
V LedMeGrow nabízíme širokou škálu pěstitelských potřeb pro indoor a outdoor pěstování rostlin. Od kvalitních grow boxů, přes široký výběr substrátů a květináčů, až po speciální hnojiva a vzduchotechniku. Naše produkty jsou navrženy tak, aby vyhovovaly potřebám každého pěstitele. Úspěch pěstování je v konzistenci a každý konzistentní zahradník se pravidelně věnuje množení rostlin, proto jsme pro vás připravili kompletní sekci s produkty pro množení a předpěstování rostlin.
#ShowMore#
Pro zahradníky, kteří se věnují hydroponii a aeroponii nebo potřebují specializované přípravky na ochranu rostlin, máme v nabídce mnoho produktů, které splní požadavky i těm nejnáročnějším. Nechybí ani měřící přístroje pro pěstování rostlin, bez kterých se pokročilejší pěstitel rozhodně neobjede.
Pro zahradníky, kteří řeší zavlažování rostlin nabízíme taktéž rozsáhlou kategorii, kde najdete vše potřebné pro udržení optimální závlahy. Pro venkovní zahrady nabízíme venkovní automatizované závlahové sety (kompatibilní systém formou DIY), které se postarají o stabilní vlhkost a klima ve vašem skleníku, nebo venkovního záhonu.
Ať už jste amatérský pěstitel nebo profesionál, v LedMeGrow najdete vše potřebné pro úspěšné pěstování. Prohlédněte si naše kategorie, nezapomeňte používat propracované filtry v našem obchodě a objevte širokou nabídku produktů, které vám pomohou dosáhnout těch nejlepších výsledků ve vašich pěstitelských projektech. Nezapomeňte, že jsme specialisté v oboru pěstebního LED osvětlení, které můžete pořídit za bezkonkurenční ceny.